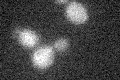
YHR168W
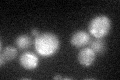
YHR168W
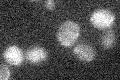
YHR168W

View description
Putative GTPase, member of the Obg family; peripheral protein of the mitochondrial inner membrane that associates with the large ribosomal subunit; required for mitochondrial translation, possibly via a role in ribosome assembly
Localization:
Intensity:
Fold change:
Significance:
-
C’ GFP library in SD
below threshold18.71 -
N' NOP1pr-GFP in SD

N/A0 -
N' TEF2pr-mCherry in SD

N/A0 -
N' NATIVEpr-GFP in SD

N/A0 -
N' TEF2pr-VC and Cyto-VN in SD

N/A0 -
C’ GFP library in SD+DTT
cytosol15.940.85No -
C’ GFP library in SD+H2O2

cytosol13.60.72No -
C’ GFP library in Starvation Media
cytosol15.660.83No -
C’ GFP library on the background of Pup2-DaMP

below threshold -
C’ GFP library on the background of CCT mutant

below thresholdN/AN/ANo
